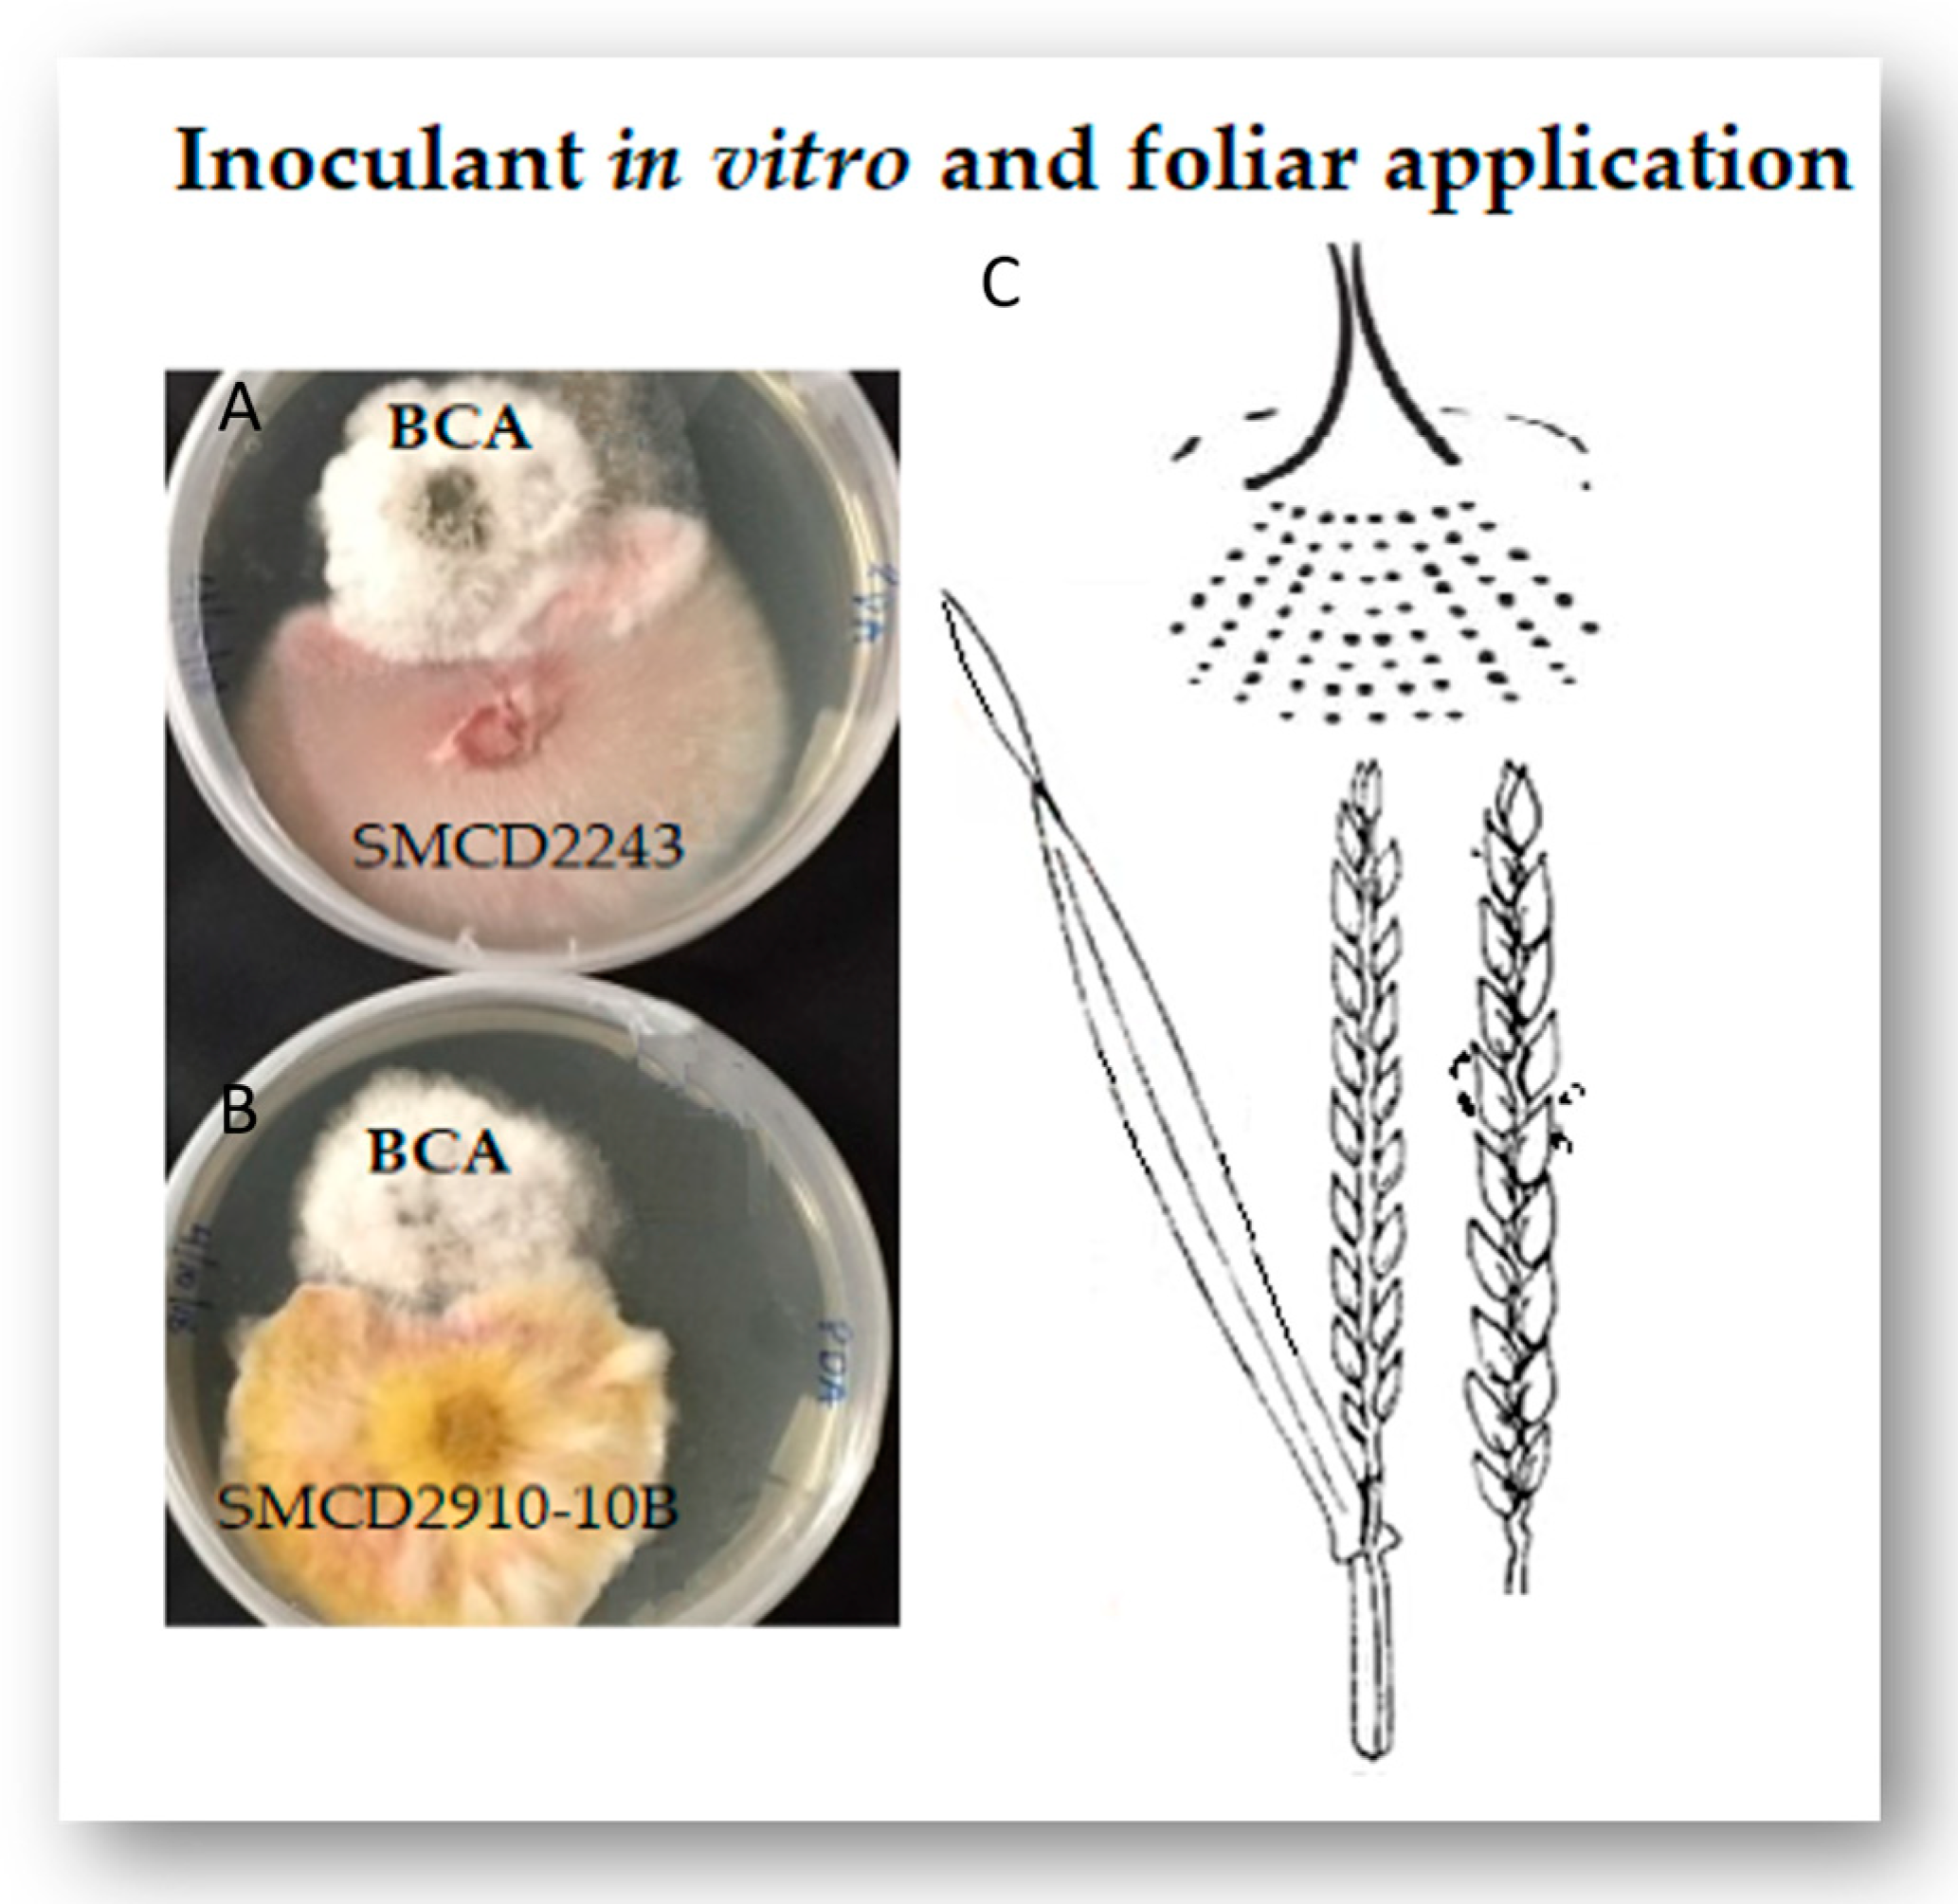
Pathogens 13 00372 g001

Insights into Wheat Genotype‒Sphaerodes mycoparasitica Interaction to Improve Crop Yield and Defence against Fusarium graminearum: An Integration of FHB Biocontrol in Canadian Wheat Breeding Programmes
Abstract
1. Introduction
2. Results
2.1. Effects of BCA Treatments on Agronomic Traits
2.1.1. Spike Number
2.1.2. Spike Weight
2.1.3. Seed Yield
2.1.4. Vegetative Plant Biomass
2.1.5. Plant Height
2.2. Fusarium Control in Susceptible vs. Resistant Cultivars
3. Discussion
3.1. BCA Effect on Agronomic Traits
3.2. Common Wheat versus Durum Wheat
3.3. BCA Effect on Fusarium graminearum in Seeds
4. Materials and Methods
4.1. Cultivars and Treatments
4.2. Greenhouse Trials and Sampling Methods
4.3. Assessment of Fusarium graminearum in Mature Harvested Seeds
4.4. Statistical Analysis
5. Conclusions
Author Contributions
Funding
Institutional Review Board Statement
Informed Consent Statement
Data Availability Statement
Acknowledgments
Conflicts of Interest
References
- FAOSTAT. World Food and Agriculture–Statistical Yearbook 2021; FAO: Rome, Italy, 2021. [Google Scholar] [CrossRef]
- Crespo-Herrera, L.A.; Crossa, J.; Huerta-Espino, J.; Vargas, M.; Mondal, S.; Velu, G.; Payne, T.S.; Braun, H.; Singh, R.P. Genetic Gains for Grain Yield in Cimmyt’s Semi-Arid Wheat Yield Trials Grown in Suboptimal Environments. Crop Sci. 2018, 58, 1890–1898. [Google Scholar] [CrossRef] [PubMed]
- Sharma, R.C.; Crossa, J.; Velu, G.; Huerta-Espino, J.; Vargas, M.; Payne, T.S.; Singh, R.P. Genetic Gains for Grain Yield in CIMMYT Spring Bread Wheat across International Environments. Crop Sci. 2012, 52, 1522–1533. [Google Scholar] [CrossRef]
- United Nations. World Population Prospects. Highlights; United Nations: Rome, Italy, 2019. Available online: https://population.un.org/wpp (accessed on 28 June 2020).
- STATCAN. Production of Principal Field Crops-Wheat 2023; Statistics Canada: Ottawa, ON, Canada, 2023. Available online: https://www150.statcan.gc.ca/t1/tbl1/en/tv.action?pid=3210035901 (accessed on 10 July 2023).
- Powell, A.J.; Vujanovic, V. Evolution of Fusarium Head Blight Management in Wheat: Scientific Perspectives on Biological Control Agents and Crop Genotypes Protocooperation. Appl. Sci. 2021, 11, 8960. [Google Scholar] [CrossRef]
- Borlaug, O.E. Wheat Breeding and Its Impact on World Food Supply. Ausl. Acad. Sci. Canberra 1968, 5-9, 1–36. Available online: https://herba.msu.ru/shipunov/school/univ_110/papers/borlaug1968_wheat_breeding.pdf (accessed on 3 December 2019).
- Hilton, A.J.; Jenkinson, T.; Hollins, W.; Parry, D.W. Relationship between Cultivar Height and Severity of Fusarium Ear Blight in Wheat. Plant Pathol. 1999, 48, 202–208. [Google Scholar] [CrossRef]
- Lahlali, R.; Kumar, S.; Wang, L.; Forseille, L.; Sylvain, N.; Korbas, M.; Muir, D.; Swerhone, G.; Lawrence, J.R.; Fobert, P.R.; et al. Cell Wall Biomolecular Composition Plays a Potential Role in the Host Type II Resistance to Fusarium Head Blight in Wheat. Front. Microbiol. 2016, 7, 910. [Google Scholar] [CrossRef] [PubMed]
- Mills, K.; Salgado, J.D.; Pierce, P.A. Fusarium Head Blight or Head Scab of Wheat, Barley and other Small Grain Crops; CFAS-Ohioline: Columbus, OH, USA, 2016; Available online: https://ohioline.osu.edu/factsheet/plpath-cer-06 (accessed on 17 February 2020).
- Hucl, P.; Briggs, C.; Graf, R.; Chibbar, R.N. Genetic Gains in Agronomic and Selected End-Use Quality Traits over a Century of Plant Breeding of Canada Western Red Spring Wheat. Cereal Chem. J. 2015, 92, 537–543. Available online: https://onlinelibrary.wiley.co (accessed on 17 February 2020). [CrossRef]
- Hucl, P.; Briggs, C.; Shirtliffe, S.; Beres, B.; Spaner, D.; Dyck, A.; Gerard, G. Increasing grain yield while maintaining baking quality in Canada Western Red Spring wheat. Can. J. Plant Sci. 2022, 102, 973–983. [Google Scholar] [CrossRef]
- Kosová, K.; Chrpová, J.; Šíp, V. Cereal Resistance to Fusarium Head Blight and Possibilities of its Improvement through Breeding. Czech J. Genet. Plant Breed. 2009, 45, 87–105. Available online: https://www.agriculturejournals.cz/artkey/cjg-200903-0001_cereal-resistance-to-fusarium-head-blight-and-possibilities-of-its-improvement-through-breeding.php (accessed on 17 February 2020). [CrossRef]
- Tshikunde, N.M.; Mashilo, J.; Shimelis, H.; Odindo, A. Agronomic and Physiological Traits, and Associated Quantitative Trait Loci (QTL) Affecting Yield Response in Wheat (Triticum aestivum L.). Front. Plant Sci. 2019, 10, 1428. [Google Scholar] [CrossRef]
- Beche, E.; Benin, G.; da Silva, C.L.; Munaro, L.B.; Marchese, J.A. Genetic Gain in Yield and Changes Associated with Physiological Traits in Brazilian Wheat during the 20th Century. Eur. J. Agron. 2014, 61, 49–59. [Google Scholar] [CrossRef]
- Graybosch, R.A.; Peterson, C.J. Genetic Improvement in Winter Wheat Yields in the Great Plains of North America, 1959–2008. Crop Sci. 2010, 50, 1882–1890. [Google Scholar] [CrossRef]
- Schauberger, B.; Ben-Ari, T.; Makowski, D.; Kato, T.; Kato, H.; Ciais, P. Yield Trends, Variability and Stagnation Analysis of Major Crops in France over More than a Century. Sci. Rep. 2018, 8, 16865. [Google Scholar] [CrossRef] [PubMed]
- Kim, S.H.; Vujanovic, V. Relationship between Mycoparasites Lifestyles and Biocontrol Behaviors against Fusarium Spp. and Mycotoxins Production. App. Microbiol. Biotechnol. 2016, 100, 5257–5272. [Google Scholar] [CrossRef] [PubMed]
- Vujanovic, V.; Islam, M.N.; Daida, P. Transgenerational role of seed mycobiome—An endosymbiotic fungal composition as a prerequisite to stress resilience and adaptive phenotypes in Triticum. Sci. Rep. 2019, 9, 18483. [Google Scholar] [CrossRef] [PubMed]
- Vujanovic, V. Tremellomycetes Yeasts in Kernel Ecological Niche: Early Indicators of Enhanced Competitiveness of Endophytic and Mycoparasitic Symbionts against Wheat Pathobiota. Plants 2021, 10, 905. [Google Scholar] [CrossRef] [PubMed]
- Vujanovic, V.; Goh, J.K. Sphaerodes mycoparasitica sp. nov., a new biotrophic mycoparasite on Fusarium avenaceum, F. graminearum and F. oxysporum. Mycol. Res. 2009, 113, 1172–1180. [Google Scholar] [CrossRef]
- Kim, S.H.; Lahlali, R.; Karunakaran, S.; Vujanovic, V. Specific mycoparasite-Fusarium graminearum molecular signatures in germinating seeds disabled Fusarium Head Blight pathogen’s infection. Int. J. Mol. Sci. 2021, 22, 2461. [Google Scholar] [CrossRef] [PubMed]
- Vujanovic, V.; Goh, Y.K. qPCR Quantification of Sphaerodes mycoparasitica biotrophic mycoparasite interaction with Fusarium graminearum: In vitro and in planta Assays. Arch. Microbiol. 2012, 194, 707–717. [Google Scholar] [CrossRef] [PubMed]
- Kim, S.; Vujanovic, V. Biodegradation and biodetoxification of Fusarium mycotoxins by Sphaerodes mycoparasitica. AMB Exp. 2017, 7, 145. [Google Scholar] [CrossRef] [PubMed]
- Goh, Y.K. Molecular and Microscopic Studies of a Fusarium-Associated Biotrophic Mycoparasite. Master’s Thesis, University of Saskatchewan, Saskatoon, SK, Canada, 2010; p. 141. Available online: https://www.researchgate.net/publication/215601739 (accessed on 17 February 2020).
- Vujanovic, V.; Kim, S.H. Adaptability of Mitosporic Stage in Sphaerodes Mycoparasitica towards Its Mycoparasitic-Polyphagous Lifestyle. Mycologia 2017, 109, 701–709. [Google Scholar] [CrossRef] [PubMed]
- Deng, Z.; Cui, Y.; Han, Q.; Fang, W.; Li, J.; Tian, J. Discovery of Consistent QTLs of Wheat Spike-Related Traits under Nitrogen Treatment at Different Developmenttages. Front. Plant Sci. 2017, 8, 2120. [Google Scholar] [CrossRef] [PubMed]
- Gurevich, A.; Saveliev, V.; Vyahhi, N.; Tesler, G. QUAST: Quality Assessment Tool for Genome Assemblies. Bioinformatics 2013, 29, 1072–1075. [Google Scholar] [CrossRef] [PubMed]
- Haidukowski, M.; Pascale, M.; Perrone, G.; Pancaldi, D.; Campagna, C.; Visconti, A. Effect of Fungicides on the Development of Fusarium Head Blight, Yield and Deoxynivalenol Accumulation in Wheat Inoculated under Field Conditions with Fusarium Graminearum and Fusarium Culmorum. J. Sci. Food Agric. 2005, 85, 191–198. [Google Scholar] [CrossRef]
- Duan, Y.; Xiao, X.; Li, T.; Chen, W.; Wang, J.; Fraaije, B.A.; Zhou, M. Impact of Epoxiconazole on Fusarium Head Blight Control, Grain Yield and Deoxynivalenol Accumulation in Wheat. Pestic. Biochem. Physiol. 2018, 152, 138–147. [Google Scholar] [CrossRef] [PubMed]
- Gao, L.; Turner, M.K.; Chao, S.; Kolmer, J.; Anderson, J.A. Genome Wide Association Study of Seedling and Adult Plant Leaf Rust Resistance in Elite Spring Wheat Breeding Lines. PLoS ONE 2016, 11, e0148671. [Google Scholar] [CrossRef] [PubMed]
- Caldwell, C.D.; MacDonald, D.; Jiang, Y.; Cheema, M.A.; Li, J. Effect of fungicide combinations for Fusarium head blight control on disease incidence, grain yield, and quality of winter wheat, spring wheat, and barley. Can. J. Plant Sci. 2017, 97, 1036–1045. [Google Scholar] [CrossRef]
- Berry, P.M.; Kendall, S.; Rutterford, Z.; Orford, S.; Griffiths, S. Historical Analysis of the Effects of Breeding on the Height of Winter Wheat (Triticum aestivum) and Consequences for Lodging. Euphytica 2015, 203, 375–383. [Google Scholar] [CrossRef]
- Martens, G.; Lamari, L.; Grieger, A.; Gulden, R.H.; McCallum, B. Comparative yield, disease resistance and response to fungicide for forty-five historic Canadian wheat cultivars. Can. J. Plant Sci. 2014, 94, 371381. [Google Scholar] [CrossRef]
- Bai, G.; Shaner, G. Management and Resistance in Wheat and Barley to Fusarium Head Blight. Ann. Rev. Phytopathol. 2004, 42, 135–161. [Google Scholar] [CrossRef] [PubMed]
- McMullen, M.; Bergstrom, G.; De Wolf, E.; Dill-Macky, R.; Hershman, D.; Shaner, G.; Van Sanford, D. A Unified Effort to Fight an Enemy of Wheat and Barley: Fusarium Head Blight. Plant Dis. 2012, 96, 1712–1728. [Google Scholar] [CrossRef] [PubMed]
- Niwa, S.; Kubo, K.; Lewis, J.; Kikuchi, R.; Alagu, M.; Ban, T. Variations for Fusarium Head Blight Resistance Associated with Genomic Diversity in Different Sources of the Resistant Wheat Cultivar ‘Sumai 3’. Breed. Sci. 2014, 64, 90–96. [Google Scholar] [CrossRef] [PubMed]
- Vujanovic, V.; Goh, Y.K. Sphaerodes mycoparasitica Biotrophic Mycoparasite of 3-Acetyldeoxynivalenol- and 15-Acetyldeoxynivalenol-Producing Toxigenic Fusarium graminearum Chemotypes. FEMS Microbiol. Lett. 2011, 316, 136–143. [Google Scholar] [CrossRef] [PubMed]
- Mesterházy, A. Types and Components of Resistance to Fusarium Head Blight of Wheat. Plant Breed. 1995, 114, 377–386. [Google Scholar] [CrossRef]
- Berraies, S.; Cuthbert, R.; Knox, R.; Singh, A.; DePauw, R.; Ruan, Y.; Bokore, F.; Henriquez, M.A.; Kumar, S.; Burt, A.; et al. High-density genetic mapping of Fusarium head blight resistance and agronomic traits in spring wheat. Front. Plant Sci. 2023, 14, 1134132. [Google Scholar] [CrossRef] [PubMed]
- Powell, A.J.; Kim, S.H.; Cordero, J.; Vujanovic, V. Protocooperative Effect of Sphaerodes mycoparasitica Biocontrol and Crop Genotypes on FHB Mycotoxin Reduction in Bread and Durum Wheat Grains Intended for Human and Animal Consumption. Microorganisms 2023, 11, 159. [Google Scholar] [CrossRef] [PubMed]
- Op De Beeck, M.; Lievens, B.; Busschaert, P.; Declerck, S.; Vangronsveld, J.; Colpaert, J.V. Comparison and Validation of Some ITS Primer Pairs Useful for Fungal Metabarcoding Studies. PLoS ONE 2014, 9, e97629. [Google Scholar] [CrossRef] [PubMed]
- de la Cuesta-Zuluaga, J.; Escobar, J.S. Considerations for Optimizing Microbiome Analysis Using a Marker Gene. Front. Nutr. 2016, 3, 26. [Google Scholar] [CrossRef] [PubMed]
- SAS/STAT®. 9.3 User’s Guide: The MIXED Procedure; SAS Institute Inc.: Cary, NC, USA, 2024; Available online: https://support.sas.com/documentation/onlinedoc/stat/930/mixed.pdf (accessed on 17 February 2020).
- SAS Institute Inc. User’s Guide: Statistics. Release 9.3; SAS Institute Inc.: Cary, NC, USA, 2012; Available online: https://books.google.ca/books?hl=en&lr=&id=biy2BQAAQBAJ&oi=fnd&pg=PA1&dq=SAS+Institute+Inc.+2012.+User%E2%80%99s+guide:+statistics.+Release+9.3.+SAS+Institute+Inc.,+Cary,+NC.&ots=xnrO9Wr2HA&sig=k_Wrlc12dSaF_pAqm9KT3-VO6hE&redir_esc=y#v=onepage&q&f=false (accessed on 17 February 2020).
- Chaiwong, N.; Rerkasem, B.; Pusadee, T.; Prom-u-thai, C. Silicon application improves caryopsis development and yield in rice. J. Sci. Food Agric. 2021, 101, 220–228. [Google Scholar] [CrossRef] [PubMed]
- Grabka, R.; d’Entremont, T.W.; Adams, S.J.; Walker, A.K.; Tanney, J.B.; Abbasi, P.A.; Ali, S. Fungal Endophytes and Their Role in Agricultural Plant Protection against Pests and Pathogens. Plants 2022, 11, 384. [Google Scholar] [CrossRef]

| Type | Treatment | Sphaerodes mycoparasitica (Sm) (2220-01) | Fungicide(F) (Prosaro) | F. graminearium (F.gr) 3ADON Mixture of Strains | Additional Notes | |||
|---|---|---|---|---|---|---|---|---|
| Treatment Number & Name | Applied at Seed | Applied at Anthesis (anth) | Applied at Seed | Applied at Anthesis (anth) | Applied at Seed | Applied AT Anthesis (anth) | ||
| 1. | Control | - | - | - | - | - | - | No biocontrol agents (BCAs) or any other treatment |
| 2. | Smseed | Yes | - | - | - | - | Yes | BCA (S. mycoparasitica 2220-01) applied to seeds only |
| 3. | SmPro seed | Yes | - | Yes | - | - | Yes | S. mycoparasitica 2220-01 + Fungicide applied to seeds (1/2 of the effective dose of fungicide; Prosaro was used) |
| 4. | Sm anth | - | Yes | - | - | - | Yes | S. mycoparasitica 2220-01 applied at anthesis |
| 5. | SmPro anth | - | Yes | - | Yes | - | Yes | S. mycoparasitica 2220-01+ Fungicide applied at anthesis |
| 6. | Fg anth | - | - | - | - | - | Yes | F. graminearum 3ADON mixture of strains applied at anthesis |
| 7. | SmX seed | Yes | - | - | - | - | Yes | S. mycoparasitica SMCD 2220-01+ SMCD 2220-02(5) mixture of BCA beneficial strains, applied to seeds |
| 8. | SmX anth | - | Yes | - | - | - | Yes | S. mycoparasitica SMCD 2220-01 + SMCD 2220-02(5) applied at anthesis |
| 9. | Sm seed + Sm anth | Yes | Yes | - | - | - | Yes | S. mycoparasitica 2220-01 applied to seeds + S.mycoparasitica 2220-01 applied at anthesis |
| 10. | SmProseed+ SmPro anth | Yes | Yes | Yes | Yes | - | Yes | S. mycoparasitica 2220-01+ Fungicide applied to seeds and S. mycoparasitica 2220-01+ Fungicide applied at anthesis. |
| F Value | ||||||
|---|---|---|---|---|---|---|
| Factor | DF | Biomass | Spikew | Spiken | Seedy | Height |
| Var | 3 | 77.31 *** | 27.09 *** | 5.16 ** | 27.39 *** | 5.59 ** |
| Trt | 9 | 2.26 * | 3.85 ** | 2.17 * | 5.07 *** | 3.66 *** |
| Var × trt | 26 | 1.56 * | 2.00 * | 1.44 ns | 2.74 *** | 3.97 *** |
Disclaimer/Publisher’s Note: The statements, opinions and data contained in all publications are solely those of the individual author(s) and contributor(s) and not of MDPI and/or the editor(s). MDPI and/or the editor(s) disclaim responsibility for any injury to people or property resulting from any ideas, methods, instructions or products referred to in the content. |
© 2024 by the authors. Licensee MDPI, Basel, Switzerland. This article is an open access article distributed under the terms and conditions of the Creative Commons Attribution (CC BY) license (https://creativecommons.org/licenses/by/4.0/).
Share and Cite
Powell, A.; Kim, S.H.; Hucl, P.; Vujanovic, V. Insights into Wheat Genotype‒Sphaerodes mycoparasitica Interaction to Improve Crop Yield and Defence against Fusarium graminearum: An Integration of FHB Biocontrol in Canadian Wheat Breeding Programmes. Pathogens 2024, 13, 372. https://doi.org/10.3390/pathogens13050372
Powell A, Kim SH, Hucl P, Vujanovic V. Insights into Wheat Genotype‒Sphaerodes mycoparasitica Interaction to Improve Crop Yield and Defence against Fusarium graminearum: An Integration of FHB Biocontrol in Canadian Wheat Breeding Programmes. Pathogens. 2024; 13(5):372. https://doi.org/10.3390/pathogens13050372
Chicago/Turabian StylePowell, Antonia, Seon Hwa Kim, Pierre Hucl, and Vladimir Vujanovic. 2024. "Insights into Wheat Genotype‒Sphaerodes mycoparasitica Interaction to Improve Crop Yield and Defence against Fusarium graminearum: An Integration of FHB Biocontrol in Canadian Wheat Breeding Programmes" Pathogens 13, no. 5: 372. https://doi.org/10.3390/pathogens13050372
APA StylePowell, A., Kim, S. H., Hucl, P., & Vujanovic, V. (2024). Insights into Wheat Genotype‒Sphaerodes mycoparasitica Interaction to Improve Crop Yield and Defence against Fusarium graminearum: An Integration of FHB Biocontrol in Canadian Wheat Breeding Programmes. Pathogens, 13(5), 372. https://doi.org/10.3390/pathogens13050372

